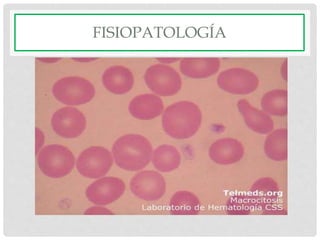
FISIOPATOLOGÍA

Este documento trata sobre la anemia. Explica que la anemia se define por la disminución de la masa eritrocitaria y que clínicamente se habla de anemia cuando disminuye el volumen de hematíes, el hematocrito o la concentración de hemoglobina. También clasifica las anemias según el tamaño del eritrocito en microcíticas, normocíticas o macrocíticas y explica que los reticulocitos son eritrocitos jóvenes cuya presencia en sangre periférica indica la función de la